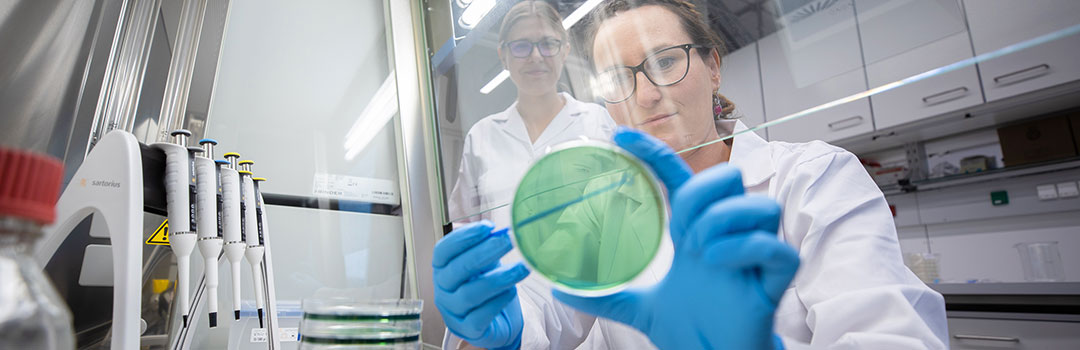
Forscherinnen mit grüner Petrischale

Forschung
Das Interesse und die Basiskompetenz des ICC Water & Health definieren sich an der vollen Breite des Themas Wasser & Gesundheit, welche mikrobiologische, chemische, toxikologische und ästhetische Aspekte der Wasserqualität widerspiegeln. Die Forschungs-Schwerpunkte sind derzeit jedoch auf mikrobiologische Aspekte der Wasserqualität fokussiert.
Unsere Publikationstätigkeit zielt einerseits auf die Erstellung qualitätsgesicherter internationaler wissenschaftlicher Publikationen (Peer Reviews) sowie andererseits auf Veröffentlichung in deutschsprachigen Medien für die Praxis ab.
Darüber hinaus wird auf nationaler und internationaler Ebene bei der Erstellung von Normen und Regelwerken mitgearbeitet.